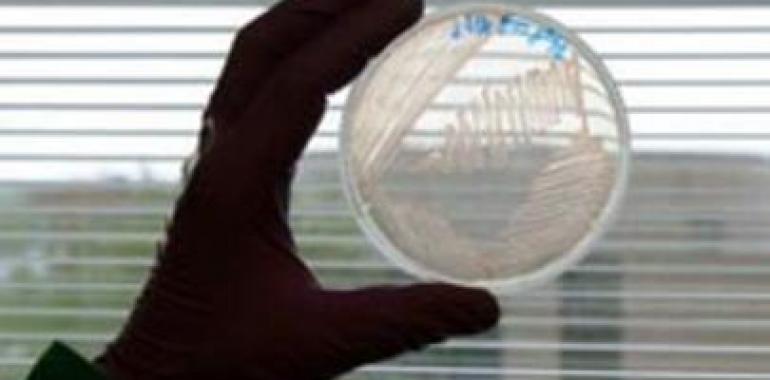

Fuente: ICEX.- La biotecnología es el principal motor del cambio tecnológico en España
Al igual que en años anteriores, la evolución biotecnológica española no se ha separado de la senda del crecimiento y ha continuado registrando un incremento en los parámetros de su facturación. Según el informe Relevancia de la Biotecnología en España 2011, elaborado por la Fundación Genoma, el sector crece anualmente en torno al 20% y la importancia de las empresas por salir al exterior -no sólo a través de filiales, sino implantándose a través de alianzas con compañías extranjeras-, ha generado que nuestro país en 2010 –últimos datos disponibles- abarcara el 3% de la producción mundial en Biociencias y el 9,9% de la producción científica europea, ocupando el 4º lugar en el ranking de la UE-15, solo por detrás de Alemania, Reino Unido y Francia, y superando por primera vez a Italia.
Actualmente, la biotecnología es uno de los sectores más dinámicos y el principal motor del cambio tecnológico en España. El tamaño del sector en nuestro país es aún minúsculo frente a otros mercados y sin embargo, los datos publicados reflejan que, durante la última década, el número de empresas españolas de biotecnología ha aumentado en torno al 359%, mientras que la facturación ha crecido un 600% hasta alcanzar los 1.429 millones de euros en 2010. Además, según la Encuesta sobre Innovación Tecnológica en las Empresas desarrollado por el Instituto Nacional de Estadística (INE), un total de 969 empresas invirtieron en I+D en el sector durante ese 2010 -un 12,9% más que el año anterior-, y el sector empresarial acrecentó un 11,2% su gasto interno en actividades de I+D relacionadas con la Biotecnología.
Estados Unidos, mercado prioritario
Alrededor del 88% de las empresas de biotecnología españolas realizaron algún tipo de actividad internacional en 2010 frente al 32% que lo hicieron en 2009, según datos aportados por la Asociación Española de Bioempresas (ASEBIO). El sector exterior está siendo una solución para muchas firmas que ven que la demanda interna no termina de recuperarse por la crisis y, el mercado estadounidense en concreto, es una prioridad dentro del área de la biotecnología ya que representa el 50% del mercado global.
Empresas como Grifols, Alphasip, Biokit, Esteve, Thrombotargets, Neocodex, Solutex, Integromics, BTI (Biotechnology Institute), Sepmag o Tecmed, por citar algunas, han apostado por la internacionalización en suelo americano a través de filiales comerciales o productivas. España es el país que mayor crecimiento ha experimentado en sus resultados de biotecnología en los últimos años y su expansión por suelo estadounidense le ha granjeado importantes reconocimientos tanto a nivel empresarial como en triunfos en el campo de la investigación.
Desde que se publicara en 1953 el artículo en la revista Nature en el que se describía la estructura molecular de ácido desoxirribonucleico, conocido popularmente como ADN, ha transcurrido toda una era. Este descubrimiento que revolucionó el mundo científico, marcó un hito en el estudio de la biología y generó la creación de una nueva industria: la biotecnología. Durante los últimos treinta años Estados Unidos ha sido el epicentro de la investigación en este campo y un gran número científicos, centros de investigación y empresas líderes están ubicados en este mercado.
En la actualidad firmas como Pharmamar –que trabaja en el tratamiento del cáncer mediante el descubrimiento, desarrollo y comercialización de medicamentos de origen marino– o Progenika –única empresa española con certificación CLIA para dar servicio de test genético en Estados Unidos– cuentan con una oficina comercial en el territorio norteamericano. Además, Neuron Biopharma, de origen andaluz, se ha establecido en Florida y es la primera empresa biotecnológica en salir al Mercado Alternativo Bursátil (MAB). Del mismo modo, Advancell, líder en investigación en nanomedicina y en métodos celulares para la investigación in Vitro, firmó un acuerdo en 2009 con la empresa americana ADMEcell para la comercialización de su reactivo CacoReadyTM en Norteamérica. Igualmente, el pasado año la empresa española Intelligent Pharma, cuyo campo de actuación engloba el desarrollo, comercialización y uso de nuevas tecnologías computacionales para el descubrimiento de fármacos, acaba colaborar tecnológicamente con la empresa californiana SciClone Pharmaceuticals, especializada en el desarrollo de fármacos en las áreas de ontología y enfermedades infecciosas.
Convención Internacional BIO 2012
Un año más Estados Unidos acoge la BIO International Convention, el evento mundial más importante para la industria biotecnológica. En el marco de la campaña “España, Technology for Life” para la Internacionalización de la Tecnología y en colaboración con la Asociación Española de Bioempresas (ASEBIO), la Fundación Genoma, y las biorregiones de Andalucía, Cataluña y País Vasco, el ICEX ha organizado la participación española en esta feria que se celebra del 18 al 21 de junio en la ciudad de Boston y al que acuden 108 expositores.
En el marco de la feria, el próximo 21 de junio, SS.AA.RR. los Príncipes de Asturias recorrerán el pabellón español y se reunirán con un grupo reducido de empresas y biorregiones.
El pabellón español está conceptualizado como un espacio ideal para que las empresas tomen contacto y establezcan relaciones comerciales y tecnológicas con el mercado americano e identifiquen a posibles socios tanto tecnológicos como comerciales. BIO es la feria internacional de referencia en el ámbito de la biotecnología y da cabida a una amplia zona de exposición y un amplio programa de conferencias y seminarios que tratan, entre otros, temas relacionados con el mundo de la agricultura y la alimentación, la medicina regenerativa, el desarrollo de negocio, el marco regulatorio, la medicina clínica y la diagnosis predictiva.
Es la novena edición en la que el ICEX participa con un pabellón oficial en este encuentro. Los expositores se encuentran distribuidos en cuatro bloques: tres de ellos representan las biorregiones de Andalucía (con 8 empresas y 7 instituciones del sector), Cataluña (32 empresas y 20 instituciones) y País Vasco (7 empresas y 23 instituciones) y el cuarto está destinado a acoger a 7 empresas y 4 instituciones de áreas geográficas que carecen de biorregión.
En esta ocasión, la superficie del espacio español en la BIO International Convention es de 613 metros cuadrados –en 2006, la primera vez que participó el ICEX junto con las empresas españolas se ocupó un área 90 metros cuadrados en el que estaban representados 12 expositores–. El pabellón español es un espacio ideal para que las empresas tomen contacto y establezcan relaciones comerciales y tecnológicas con el mercado americano. Además se contará con un sistema de entrevistas one-to-one en el que poder identificar socios tantos tecnológicos como comerciales, jornadas técnicas y mesas redondas temáticas organizadas en el marco de la feria.
El ICEX ha desarrollado un Plan Sectorial de Biotecnología en Estados Unidos, al que se acogen la mayor parte de las empresas participantes en la convención. Durante las ocho ediciones anteriores la participación español ha ido cosechando éxitos comerciales y ha ido ganando confianza para cruzar el gran charco y desarrollar actividad comercial e investigadora en Estados Unidos cuando en el pasado, por cercanía, se decantaba por mercados como Alemania, Reino Unido, Francia e Italia.